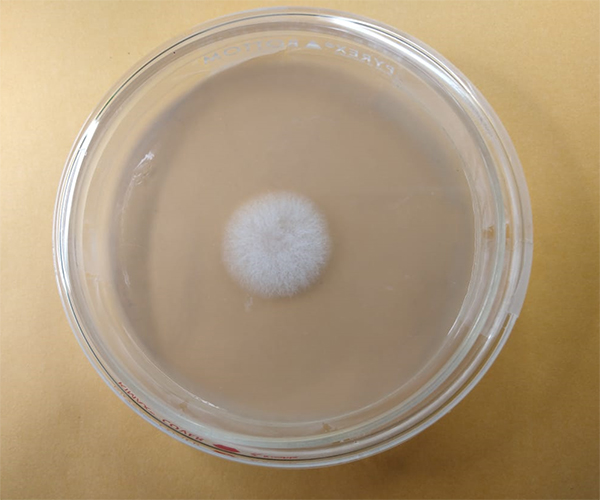
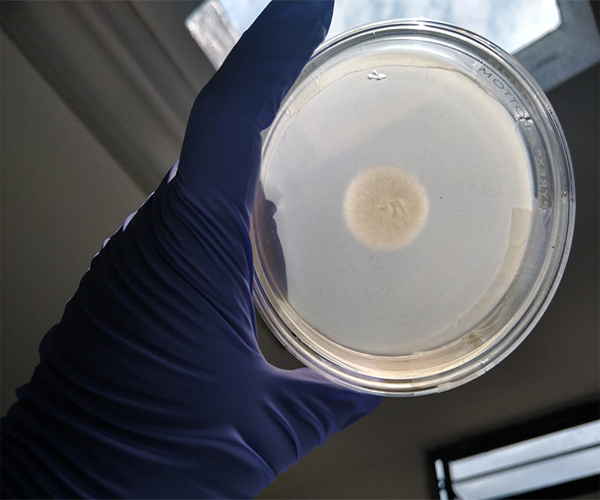

Área de Micología
Los hongos fitopatógenos son de suma importancia dentro de la producción agrícola, ya que pueden afectar a las plantas en algún momento, durante sus diferentes fases de desarrollo; cosecha y poscocecha, generando cuantiosas pérdidas económicas en campo y almacenes. Los hongos cuentan con más de 8000 especies que ocasionan enfermedades en productos y subproductos vegetales. El confiable y oportuno diagnóstico de hongos, ayuda a tener un control efectivo de estos, minimizando pérdidas económicas y proporcionando mayor calidad de los productos agrícolas.